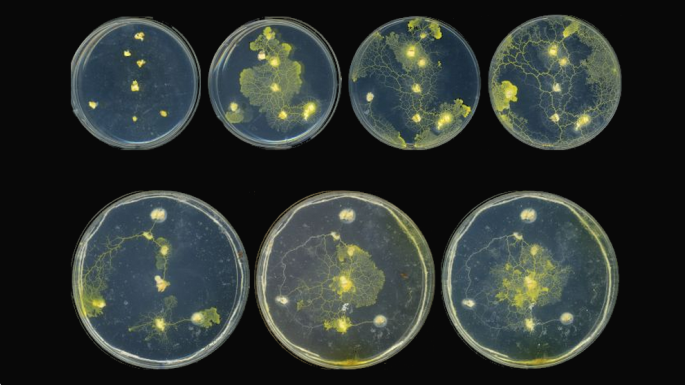
Server Farm

Server Farm
2022
Imagine a farm. Fields of dense green crops, rows of sprouting seedlings, orchards of blossoming trees, and land set aside for hedgerows and wildflowers. This farm is both sustainable and regenerative: it grows everything it needs on site, and a surplus to return to the earth. But this farm does not more than produce; it computes. Tree and crop, fungus and flower work together to answer questions we have yet to formulate.
SERVER FARM is a proposal to build a computer out of, and in collaboration with, plants and other critters.
All of the component parts of contemporary computation, from information storage, retrieval, and processing, to networking, power supply and management, input/output and display, can be replaced with biological systems. In doing so, we may find ways to ask questions, and answer them, which binary digital systems are incapable of even describing.
Emerging from cross-disciplinary work in biology, agronomy, and artistic practice, SERVER FARM seeks to establish the complete circuit of information technology in fields, orchards, and gardens: an actual agricultural establishment which acquires, stores, processes, displays, and shares data, while at the same time repairing the biosphere and more-than-human relationships.
Information technology, as presently configured, is a huge contributor to CO2 emissions, as well as being complicit in a range of oppressive, extractive, and neo-colonial industrial processes which damage the planet, its ecosystems and denizens, and human society. Yet technology itself, in the forms of seeing, describing, and acting upon the world which it enables, remains an essential part of human thriving, and a necessary tool for addressing the damage we have already inflicted.
From encoding information in DNA to mapping algorithms with slime molds; from mycelial networks to carbon sequestration; and from heavy metal hyperaccumulators to permaculture processing; the tools and knowledges exist right now to wholly replace the toxic technological infrastructures of the present with decentralised, rooted and regenerative alternatives.
SERVER FARM is a vision for bringing together these diverse but cumulative realisations, and a robust proposal for grounding them in the earth. Moving from discussions and experiments with artists, scientists, and other researchers towards a fully established, working farm, it embodies and enacts the kinds of relationships with one another and the more-than-human world which are of such urgency in the present moment.
→ More information: serverfarm.jamesbridle.com
→ Read the story: Rebooting the Server Farm
→ First iteration: Test Plot 001